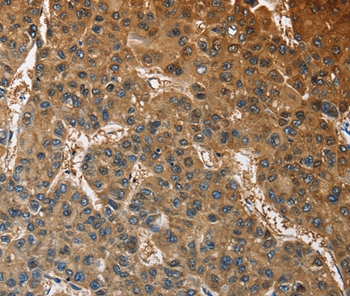
Rabbit Polyclonal Antibody to ATP1B2

提醒成功

搜索
Rabbit Polyclonal Antibody to ATP1B2
-
货号:
P42812 -
别名:
AMOG -
应用:
IHC -
反应种属:
Human -
抗体类型:
Primary antibody -
Swissprot:
P14415 -
规格:
-
数量:
-+ -
说明书:
目录价¥1980

Rabbit Polyclonal Antibody to ATP1B2
Description |
|---|
The protein encoded by this gene belongs to the family of Na+/K+ and H+/K+ ATPases beta chain proteins, and to the subfamily of Na+/K+ -ATPases. Na+/K+ -ATPase is an integral membrane protein responsible for establishing and maintaining the electrochemical gradients of Na and K ions across the plasma membrane. These gradients are essential for osmoregulation, for sodium-coupled transport of a variety of organic and inorganic molecules, and for electrical excitability of nerve and muscle. This enzyme is composed of two subunits, a large catalytic subunit (alpha) and a smaller glycoprotein subunit (beta). |
Specification |
|
|---|---|
| Aliases | AMOG |
| Entrez GeneID | 482; |
| Swissprot | P14415 |
| Host/Isotype | Rabbit IgG |
| Antibody Type | Primary antibody |
| Storage | Store at 4°C short term. Aliquot and store at -20°C long term. Avoid freeze/thaw cycles. |
| Species Reactivity | Human |
| Immunogen | Fusion protein corresponding to a region derived from internal residues of human ATPase, Na+/K+ transporting, beta 2 polypeptide |
| Formulation | Liquid in PBS containing 50% glycerol, 0.5% BSA and 0.02% sodium azide. |
Application |
|
|---|---|
| IHC | 1/25-1/100 |
Product Image
For Reseach Only
Application Key:WB - Western Blot | IHC - Immunohistochemistry | ICC - Immunocytochemistry | FCM - Flow Cytometry | ELISA - Enzyme-linked Immunosorbent Assay | IP - Immunoprecipitation
#P42812

相关产品















 微信/QQ登录
微信/QQ登录


 首页
首页